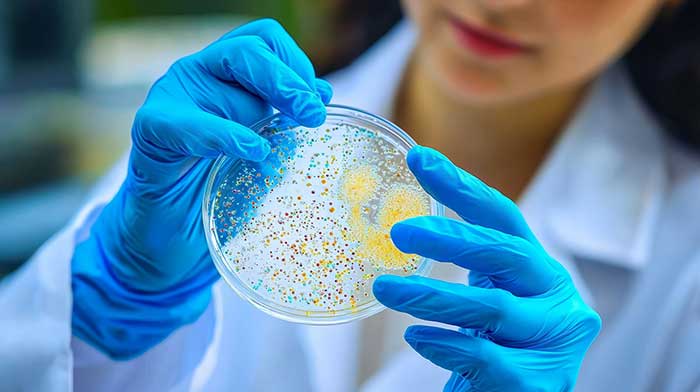

Cancer Research
Discover how our research drives innovation — from studying cancer at the cellular level to developing new therapies and bringing breakthroughs directly to patients through clinical trials.
Our scientists and clinicians foster an environment of innovative thinking and collaboration to enhance patient care.
Science and research are integral to who we are at the WVU Cancer Institute. By cultivating interactions between basic, clinical, and population researchers, our scientific programs are designed to address the unique needs and health disparities of West Virginia and the surrounding region. Our interdisciplinary team works across the cancer continuum in areas of the cause of disease, prevention, early detection, treatment, recurrence, and survivorship.
Harnessing the power of the West Virginia University Health Sciences Center, we use the expertise of more than 80 scientific members from 33 departments and eight schools to conduct cancer-related research and improve outcomes for cancer patients. Our research portfolio includes peer-reviewed grants, as well as foundation and industry funding.
To provide the highest quality of cancer research, we need a deep understanding of clinical problems. That is why we engage physician scientists, who work with patients and foster collaboration with basic scientists to attack problems in the lab. Discoveries are then translated for patients and the general public through education and community engagement.
As the leader in oncology clinical trials in our region, we are dedicated to giving our patients access to the most innovative breakthroughs in cancer care. Our work helps save lives and improve patient outcomes today while paving the way for new, life-changing discoveries in the future.

Clinical Trials
The Clinical Research Unit is dedicated to providing the services needed to conduct clinical trials and expand the growing body of biomedical knowledge.

Research Programs and Labs
WVU Cancer Institute research programs combine the activities of investigators who have common scientific interests and goals.
Highlighted Researchers
Learn more
Ivan Martinez, PhD

Ashkan Emadi, MD

Dannell Boatman, EdD

Shared Research Resources
The Clinical Research Unit at the Mary Babb Randolph Cancer Center collaborates with other core facilities to support the clinical research enterprise.
Membership
The WVU Cancer Institute welcomes applications from all faculty who have cancer-related research interests.
